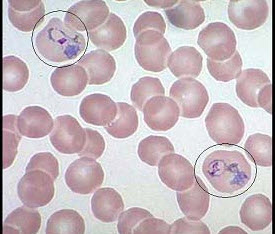

如图,圈中所示红细胞中的异常结构为()
A .卡波环
B .嗜碱性点彩红细胞
C .H-J小体
D .网织红细胞
E .疟原虫
参考答案与解析:
-
相关试题
-
如图,圈中所示红细胞中的异常结构为()
-
[单选题]如图,圈中所示红细胞中的异常结构为()A . 卡波环B . 嗜碱性点彩红细胞C . H-J小体D . 网织红细胞E . 疟原虫
- 查看答案
-
图中所示红细胞异常结构为()
-
[单选题]图中所示红细胞异常结构为()A . H-J小体B . 杜勒小体C . 嗜碱性点彩红细胞D . 疟原虫E . 网织红细胞
- 查看答案
-
图中所示红细胞异常结构为()
-
[单选题]图中所示红细胞异常结构为()A .H-J小体B .杜勒小体C .嗜碱性点彩红细胞D .疟原虫E .网织红细胞
- 查看答案
-
如图,若圈中所示红细胞为12%,可排除哪种贫血()
-
[单选题]如图,若圈中所示红细胞为12%,可排除哪种贫血()A . 不稳定血红蛋白病B . 再生障碍性贫血C . 遗传性球形红细胞增多症D . G-6-PD酶缺乏症E . 海洋性贫血
- 查看答案
-
如图,若圈中所示红细胞为12%,可排除哪种贫血()
-
[单选题]如图,若圈中所示红细胞为12%,可排除哪种贫血()A .不稳定血红蛋白病B .再生障碍性贫血C .遗传性球形红细胞增多症D .G-6-PD酶缺乏症E .海洋性贫血
- 查看答案
-
如图所示的异常红细胞结构为()
-
[多选题] 如图所示的异常红细胞结构为()A . 嗜碱性点彩红细胞B . H-J小体C . 网织红细胞D . 疟原虫E . 卡波环
- 查看答案
-
如图所示的异常红细胞结构为()
-
[多选题] 如图所示的异常红细胞结构为()A .嗜碱性点彩红细胞B .H-J小体C .网织红细胞D .疟原虫E .卡波环
- 查看答案
-
如图,若外周血圈中所示红细胞增多,最常见于()
-
[单选题]如图,若外周血圈中所示红细胞增多,最常见于()A . 白血病B . 缺铁性贫血C . 溶血性贫血D . 骨髓病性贫血E . 再生障碍性贫血
- 查看答案
-
如图,若外周血圈中所示红细胞增多,最常见于()
-
[单选题]如图,若外周血圈中所示红细胞增多,最常见于()A .白血病B .缺铁性贫血C .溶血性贫血D .骨髓病性贫血E .再生障碍性贫血
- 查看答案
-
如图,圈中所示红细胞中的异常结构为()<img border="0" style="width: 280px; height: 240px;" src=&
-
[单选题]如图,圈中所示红细胞中的异常结构为()A.卡波环B.嗜碱性点彩红细胞C.H-J小体D.网织红细胞E.疟原虫
- 查看答案
